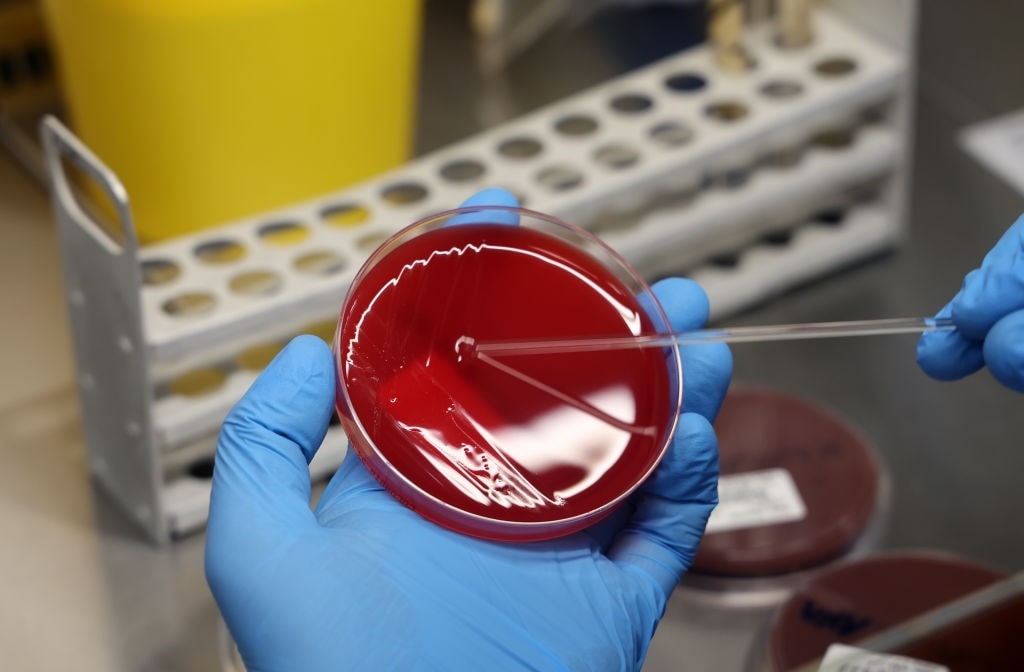

THE AMERICA ONE NEWS

Oct 8, 2025 |
0
| Remer,MNSponsor: QWIKET
Sponsor: QWIKET
Sponsor: QWIKET: Sports Knowledge
Sponsor: QWIKET: Elevate your fantasy game! Interactive Sports Knowledge.
Sponsor: QWIKET: Elevate your fantasy game! Interactive Sports Knowledge and Reasoning Support for Fantasy Sports and Betting Enthusiasts.
topic
America One News
24 May 2024
#politics
The Western Journal: Biden's Weaponized DOJ Targets Pro-Life Activists with New Lawsuit
DOJ targets pro-life activists for interference at Ohio abortion clinics. FACE Act violations at root of lawsuit.
Forbes: Colleges Face Tidal Wave Of Lawsuits Over Gaza Protests
Pro-Palestinian student groups sue Columbia for suspension. Nationwide college protests stir debate on free speech vs protest limits. Civil Liberties vs Civil Rights in campus politics.
#war
#foreignaffairs
Fox News: UN court demands Israel halt Rafah offensive, but government vows 'we will destroy Hamas'
The United Nations orders Israel to stop military offensive in Rafah, Gaza amid ongoing conflict with Hamas. Netanyahu vows to continue operation to ensure security, despite court's ruling. Hamas accused of holding hostages and causing mass displacement. Netanyahu compares situation to WWII standoff.
Breitbart: Dem Rep. Bera: A Ceasefire Won't Happen Until Hamas' Military Wing Is Destroyed
Rep. Bera warns of no ceasefire with Hamas’ military wing. Pushes for new Palestinian leadership for peace.
Forbes: Putin Ready For Ceasefire In Ukraine On Current Frontlines, Report Says—Here’s What Russia Would Gain
Vladimir Putin ready to freeze war in Ukraine, claiming occupied territories as Russian. Zelensky rejects terms, seeks peace on different terms.
Fox News: Trial set for UK men accused of collaborating with Hong Kong intelligence service
Hong Kong office manager and another man on trial in U.K. for aiding intelligence gathering. Third suspect found dead. Chinese officials slam charges as political manipulation.
Breitbart: IDF Recovers Three More Bodies of Israeli Hostages in Gaza
The bodies of three hostages, victims of the October 7 Massacre, were rescued in Gaza by IDF and ISA in exchange for official announcements. Israel vows to retrieve other 125 hostages still held in Gaza.
#economy
Breitbart: NBC: Buying a Home Harder Than It's Been in a Decade, Average Home Unaffordable by Nearly $70K
In the gritty world of homebuying, NBC's new index reveals an uphill battle for buyers. With prices soaring and inventory tight, the average home is almost $70,000 beyond reach. Experts predict no relief in sight, with mortgage rates holding steady at 7%.
#culture
The Telegraph: Super Size Me star who exclusively dined on McDonald’s dies of cancer
Oscar-nominated director of Super Size Me, Morgan Spurlock, dies at 53 from cancer. Documentary led to public debate on fast food industry.
Fox News: Morgan Spurlock, 'Super Size Me' director, dead at 53
Documentary filmmaker Morgan Spurlock has died at 53 from cancer. Brother Craig Spurlock remembers him as a creative genius.
Fox News: Morgan Spurlock, 'Super Size Me' director dead at 53
Documentary filmmaker Morgan Spurlock has died at 53 from cancer. Brother Craig Spurlock remembers him as a creative genius.
#health
The Western Journal: Pfizer Settles More Than 10,000 Cancer Suits in Bid to Reduce Potential Liability
Pfizer settles 10,000 cancer lawsuits for drug Zantac, facing hidden risks accusations. Vaccines like Comirnaty won't face similar legal battles due to immunity laws. Big Pharma faces scrutiny over products' safety.
Fox News: What to know about the new 'FLiRT' COVID variants
According to the World Health Organization, the FLiRT variants are dominant globally. CDC data shows a decrease in COVID-related hospitalizations and flat rates in emergency departments.
The FLiRT variants of the SARS-CoV-2 virus are prevalent globally in 2024. Health experts discuss the effectiveness of current vaccines against these new variants, with a planned meeting on vaccine design on June 5.
#crime
Fox News: Hunter Biden is in court in Delaware. Here's what he doesn't want the jury to hear
Hunter Biden faces trial for federal gun charges in Delaware, aiming to block prosecutors from using certain evidence about his past. Defense requests exclusion of details like child support and Navy discharge. Trial set for June 3, despite defense's attempt to delay. Defense argues against presenting 'prejudicial' evidence to the jury.
The Western Journal: Rashida Tlaib Staffer Accused of Assaulting Fox News Cameraman During Interview: 'We Have It on Video'
Dem. Rep. Rashida Tlaib's aide assaulted a Fox News cameraman, using an umbrella to block questions on Israeli PM Netanyahu's address to Congress. Tlaib denies responsibility.
#science
#other
Fox News: 'Wheel of Fortune' contestant goes viral for x-rated answer: 'Will be played for eternity'
A "Wheel of Fortune" contestant made headlines with a raunchy guess. Host Pat Sajak corrected the answer, leading to humorous reactions.